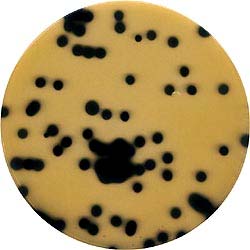

TSC Agar (Tryptose Sulfite Cycloserine Agar), Base - Mikrobiyoloji
TSC Agar (Tryptose Sulfite Cycloserine Agar), Base
TSC Agar Katkısı (Merck 1.00888)
Clostridium perfringens Supplement
TSC Agar besiyerine Clostridium perfringens Supplement ilave edildiğinde siyah kolonilerin etrafında floresan ışıma görülür.
TSC Agar hakkında daha fazla bilgi almak için burayı tıklayın.
Bu katkı kullanılmadan TSC Agar besiyerinde Clostridium perfringens kolonilerinin fotoğrafı
Bu sayfa 8147 kez okundu.